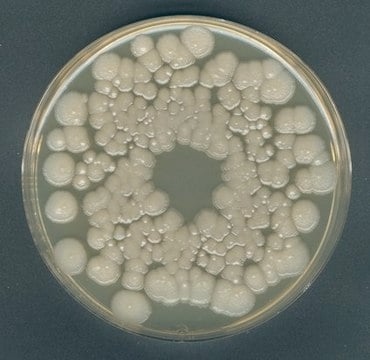

Merck, Orange Serum agar 500gr
NACRES: NA.74 UNSPSC Code: 41106213 Manufacturer/tradename: GranuCult® prime Agency: according to IFU Ph: 5.4-5.6 (37 °C, 42 g/L in H2O, after autoclaving) Form: granular Suitability: molds, yeasts Application(s): food and beverages microbiology
